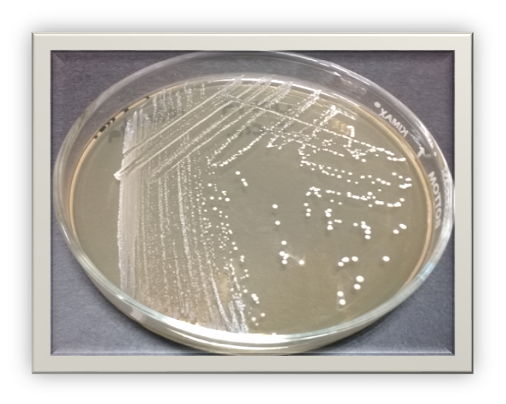

1/6. #2021BNT #RedBio #IPN. Nodo Escuela Nacional de Ciencias Biológicas-IPN.
Integrantes de la Red de Biotecnología del Nodo de la ENCB del Instituto Politécnico Nacional solicitaron el registro de una patente ante el IMPI, la cual fue otorgada en 2008
Integrantes de la Red de Biotecnología del Nodo de la ENCB del Instituto Politécnico Nacional solicitaron el registro de una patente ante el IMPI, la cual fue otorgada en 2008

2/6. Bacterias ácido-lácticas. Integrantes de la Red de Biotecnología del Nodo de la ENCB del IPN descubrieron que la cepa Lactobacillus sanfranciscensis LBH1068 aislada del sedimento del pulque es posiblemente útil en el tratamiento de una enfermedad inflamatoria intestinal. 







3/6. Resveratrol y la conducta. Integrantes de la Red de Biotecnología del Nodo de la ENCB del IPN divulgaron que el resveratrol es un complemento alimenticio y sirve para prevenir deficiencias de la conducta; una fuente del resveratrol es la uva y por ende el vino de mesa. 



4/6. Patente Internacional. Integrantes de la Red de Biotecnología del Nodo de la ENCB del IPN participaron en la patente internacional titulada “New probiotic strain of Lactobacillus brevis” bacteria ácido láctica aislada del pulque con propiedades anticancerigenas.

5/6. Alimentos funcionales.Integrantes de la Red de Biotecnología del Nodo de la ENCB del IPN solicitaron ante el IMPI el registro de la patente de “Jalea con pericarpio de tamarindo con actividad antioxidante y probiótica y su proceso de obtención” MX/a/2020/013944. 





6/6. Coordinadora de Nodo ENCB del IPN. Dra. María Elena Sánchez Pardo. Contacto: alimentoselena@hotmail.com 

• • •
Missing some Tweet in this thread? You can try to
force a refresh



